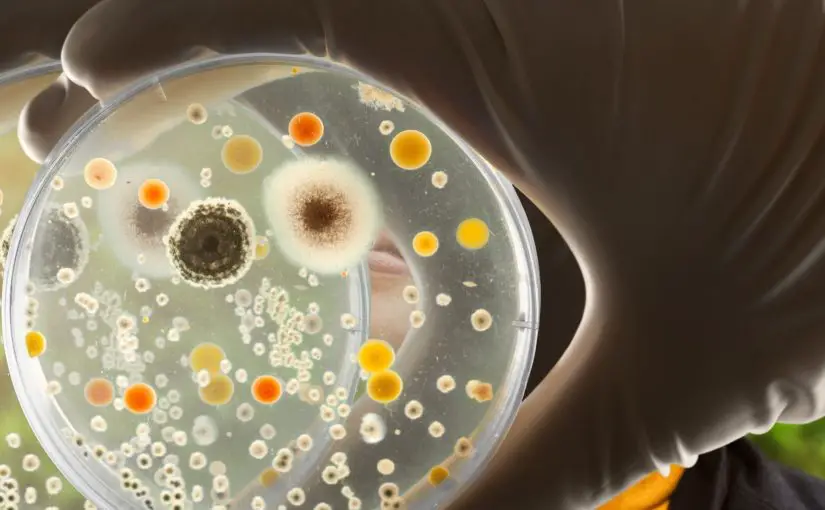

Should You Place Your Humidifier on the Floor or Nightstand?
Whether to place your humidifier on the floor or on an elevated surface like a nightstand depends on several factors. The ideal location balances the humidifier’s mist distribution with convenience of use and potential safety hazards. Carefully considering the type of humidifier, size of space, and your goals for humidity can lead to an optimal setup.
Floor placement takes advantage of a cool mist’s tendency to fall and disperse across a room. Warm mist and ultrasonic models often work better at height to distribute microfine droplets. However, any location risks leaks damaging furnishings or finishes. Monitoring water levels is also more difficult low to the ground. A higher perch makes maintenance easier but warm mist could cause burns and unstable units may tip over. Test different spots to find the best positioning for performance, safety, and ease of use in your unique space.
Recommended Products:
| “Over-All” Best Humidifier Levoit LV600 see on Amazon |
 |
| Runner Up Dreo Smart Humidifier view Here |
 |
| #1 Anti -Microbial Mold Resistant Humidifier PureGuardian H5450BCA view on Amazon |
 |
Humidifier Types and Their Ideal Positions
The four main types of humidifiers have distinct mist properties that factor into placement:
| Type | Ideal Position |
|---|---|
| Cool Mist | Floor level to disperse visible mist |
| Warm Mist | Elevated at safe height for warm steam |
| Ultrasonic | Slightly elevated to spread microfine mist |
| Evaporative | Floor level to take advantage of natural air current |
Cool Mist Humidifiers
Cool mist models release a visible, billowing spray. The heavy mist falls quickly to the floor, which makes low placement ideal. Positioning the unit just above the ground allows the moisture to disperse throughout the room efficiently. Having it in the breathing zone also directs hydration where you need it most when sleeping or lounging. Just be sure to allow adequate clearance so that mist doesn’t get blocked.
Warm Mist Humidifiers
Warm mist humidifiers vaporize water to a hot steam. This lightweight moisture floats up in the air readily. Placing warm mist models on the floor wastes much of the steam. Positioning them on an end table or nightstand at waist to chest level lets the mist disseminate. Just don’t situate it so high that the hot vapor causes burns. Also beware of placing near any furniture, drapery, or bedding that could be damaged by the steam.
Ultrasonic Humidifiers
Ultrasonic devices create a microfine cool mist. Without any visible spray, it’s hard to determine where the nearly invisible moisture is traveling. Some experimentation with height may be needed. If placed too low, the microparticles float up instead of dispersing downward. Try elevating an ultrasonic unit off the floor about 12-18 inches. This allows the mist to billow out to cover the room better. Adjust the direction of the mist output for wider coverage as needed.
Evaporative Humidifiers
Evaporative models rely on a fan to blow air across a wet wick filter. The natural airflow in a room helps circulate the moisture. Situate an evaporative humidifier low to the ground so the humidity can be easily whip up by air currents. Near a corner also allows air to pick up moisture in two directions. Just don’t block the fan’s intake or outtake while still leaving space for filters to be removed.
6 Factors to Consider for Humidifier Placement
Beyond the type of humidifier, several other factors impact the ideal placement in your unique space.
1. Coverage Area and Misting Direction
Consider the output and range of your humidifier first. Cool mist and ultrasonic options often have adjustable vents to control mist direction. Pointing the vapor up or down changes where moisture is focused. Wide spaces may need multiple units placed in opposite corners to humidify effectively. Turning or adjusting the humidifier aims the mist for whole room coverage.
2. Visibility of Water Level
Refilling the water tank is essential for continuous operation. Placing the humidifier low to the floor makes this tough to see. Lifting or tilting the unit can give a view inside to gauge water level. Or allow space to pull the humidifier forward to view the tank. Top-filling and transparent models make checking easier at any height.
3. Potential Safety Issues
Burns, leaks, mold, and bacteria are hazards to weigh. Warm mist especially calls for care around kids and pets. Leaks could damage flooring, furniture or bedding so consider moisture absorption. Keep sufficient distance from electronics and assets. Also check that the surface can handle the humidifier’s weight and vibration without tipping.
4. Aesthetics and Clutter
Finding a discreet spot to tuck the humidifier out of sight can be ideal. This prevents it from causing clutter on tabletops and dressers. Placing units behind furniture or in corners keeps them out of the way. Just don’t hide them so much that the mist gets blocked or operation gets disrupted.
5. Accessibility for Refilling and Cleaning
Since humidifiers require frequent filling and cleaning, give yourself adequate space to maneuver them. Allow room to remove covers, pull out tanks or trays, change filters, and empty excess water. Don’t shove the unit too tightly into a niche where access is limited. Give yourself elbow room for maintenance.
6. Convenience of Use
Think about how high or low you want humidifier controls and displays. Digital panels are often easier to read at eye level. But don’t put warm mist options so high that reaching the dials risks burns. Place it for easy function whether standing or lying in bed. Cord length should also allow for accessible outlet access.
 Pros and Cons of Placing Humidifiers on the Floor
Pros and Cons of Placing Humidifiers on the Floor
Setting your humidifier directly on the floor has some distinct advantages but also poses a few drawbacks to consider:
Potential Advantages
- Allows cool mist and evaporative humidifiers to disperse moisture at low levels
- Puts humidification into breathing zone when used in bedroom
- Safer setup for warm mist units to avoid burns from high placement
- Provides stability and reduces risk of tipping over
- Can partially hide unit behind furniture or in corner
Potential Disadvantages
- Harder to see water level for refilling
- More risk of leaks damaging flooring or carpets
- Pets or children may tamper with controls
- Collects more dust and dirt at ground level
- Cord can pose tripping hazard
Tips for Floor Placement
- Put humidifier in a corner to distribute mist widely
- Keep cord tucked safely away from walking areas
- Use leak-proof mats or trays underneath
- Check water level by lifting or tilting unit
- Allow space for mist to disseminate
Pros and Cons of Putting Humidifiers on Nightstands
Elevating your humidifier on a table, nightstand or dresser has some positives but a few drawbacks too:
Potential Advantages
- Easy to see and reach controls and water level
- Less risk of leaks damaging flooring
- Mist distributes well for ultrasonic models
- Visible mist and lights if equipped
- Convenient access next to bed
Potential Disadvantages
- Warm mist risks burns if placed too high
- Ultrasonic mist may miss lower breathing zone
- Prone to tipping over if bumped
- Takes up valuable tabletop space
Tips for Elevated Placement
- Use sturdy surface at comfortable height
- Aim mist output for full coverage
- Keep humidifier back from table’s edge
- Secure cord neatly to prevent tripping
- Monitor water level and refill frequently
Other Humidifier Placement Tips
In addition to elevation, also factor in these tips for ideal humidifier positioning:
- Room Size – Use multiple units for very large spaces
- Airflow – Avoid blocking vents or fans
- Furnishings – Allow ample clearance from walls and objects
- Surfaces – Use waterproof platforms if concerned about leaks
- Maintenance – Leave space for cleaning and servicing
- Refilling – Situate near water source or drainage
- Humidity Needs – Adjust placement to meet your desired moisture levels
Specific Placement Examples
To give you a better idea for real-world placement, here are some examples in common spaces:
Bedroom Setup
- Cool mist humidifier on nightstand or floor by bed
- Warm mist model on dresser across room
- Ultrasonic option on shelf above headboard
Living Room Arrangement
- Evaporative unit tucked discreetly behind sofa
- Cool mist model in far corner by window
- Warm mist on side table away from foot traffic
Baby Nursery Positioning
- Cool mist on floor in crib corner
- Ultrasonic humidifier elevated on chest of drawers
- Warm mist kept high up and far from reach
Home Office Spots
- Small ultrasonic humidifier on computer desk
- Evaporative unit on floor under desk
- Cool mist model on file cabinet behind you
Key Takeaways on Humidifier Placement
- Cool mist and evaporative models work best on the floor
- Warm mist and ultrasonic options are better elevated
- Factor in room size, mist direction, and coverage area
- Monitor safety, convenience, aesthetics, and ease of use
- Allow proper clearance from walls, furniture, and walking paths
- Experiment with different heights and locations to optimize moisture dispersion
Achieve Ideal Humidity and Convenience
Finding the right spot for your humidifier takes some planning and experimenting. Consider the limitations and benefits of both floor and elevated positions. Test out placements at different heights while observing mist direction. This helps dial in the ideal arrangement for whole room humidity. Monitor comfort, safety, and ease of use as you fine-tune the positioning. With strategic testing, you can determine the best humidifier placement for your needs.


 Pros and Cons of Placing Humidifiers on the Floor
Pros and Cons of Placing Humidifiers on the Floor


 Conclusion
Conclusion

 Signs the Filter Needs Replacement
Signs the Filter Needs Replacement

 Tips for Using Humidifiers Safely
Tips for Using Humidifiers Safely
 What is Humidity and Why is it Important to Control in Your Home?
What is Humidity and Why is it Important to Control in Your Home? What is the Ideal Humidity Level for Homes?
What is the Ideal Humidity Level for Homes? Ways to Increase Low Humidity Under 30%
Ways to Increase Low Humidity Under 30%
Bacteria Buildup in Stagnant Water
Bacteria Buildup in Stagnant Water
